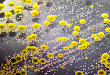

-
-
2021.03.05血培养表葡怎么打,先打假!
某日有热心网友发来一张血培养报告单(图1),问怎么打,选用什么抗生素。图1 血培养报告单答:临床遇到血培养表葡阳性,先不考虑怎么打,第一步是“打假”:正确解读...
-

-
2021.02.03远远看别人杀了一次鸭子,怎么就得重症肺炎了呢?
患者,女,52 岁,既往体健,因「乏力 20 余天,发热伴干咳、胸闷 10 余天」于 2021-01-07 入我科
-

-
2020.12.15人免疫球蛋白在免疫缺陷病中的应用
免疫球蛋白(lg)是由被B细胞分化出的浆细胞产生的抗体
-

-
2020.08.21单克隆抗体、小分子激酶抑制剂和细胞治疗诱发感染?
近年来,化疗、免疫调剂治疗、造血干细胞移植和固体器官移植的出现已彻底改变了恶性肿瘤、自身免疫性疾病和终末期器官衰竭患者的管理
-

-
2020.02.12哈佛医学院专家:治疗新冠肺炎,清除病毒和炎症管理要双管齐下
潜伏期「起得来」、进展期「控得住」、康复期「退得快」,应该成为新型肺炎防治和康复高度关注的新问题。
-

-
2020.02.11新冠病毒检测,警惕气溶胶感染风险
自 2019 年 12 月以来,湖北省武汉市持续开展流感及相关疾病监测,发现多起病毒性肺炎病例,诊断为病毒性肺炎/肺部感染,此新型病毒命名为「2019-nCoV」,该病毒...
-

-
2020.02.07硬核抗「疫」在行动 知名药企已向 17 个省份的 103 家医院直接捐赠抗疫药品
继 1 月 27 日向中国红十字总会捐款用于支援武汉市雷神山医院建设后,济民可信集团已向 17 个省份的 103 家医院捐献了多批抗疫药物。
-

-
2020.02.06从火神山到雷神山,他们与武汉同心抗「疫」
百特提供价值近 440 万人民币的医疗救援物资及现金,驰援武汉。
-

-
2020.02.01心理关爱免费义诊,抗击疫情不恐慌!
整个春节在疫情的笼罩下,你是否陷入焦虑、恐慌?
-

-
2020.01.09武汉不明原因肺炎,病原体初步判定为新型冠状病毒!
重要的 6 点
- os
